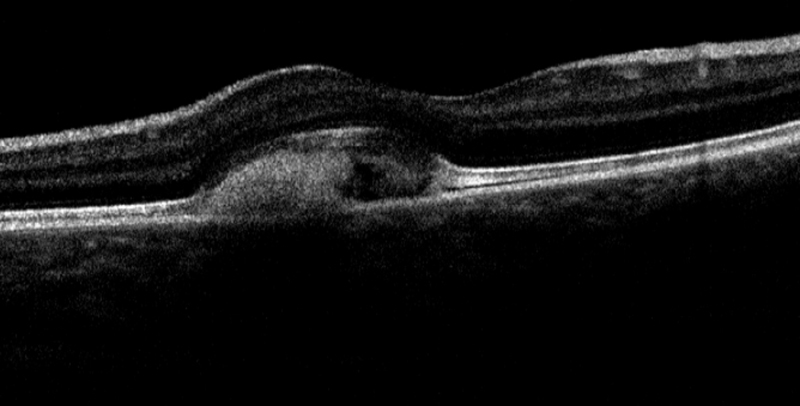
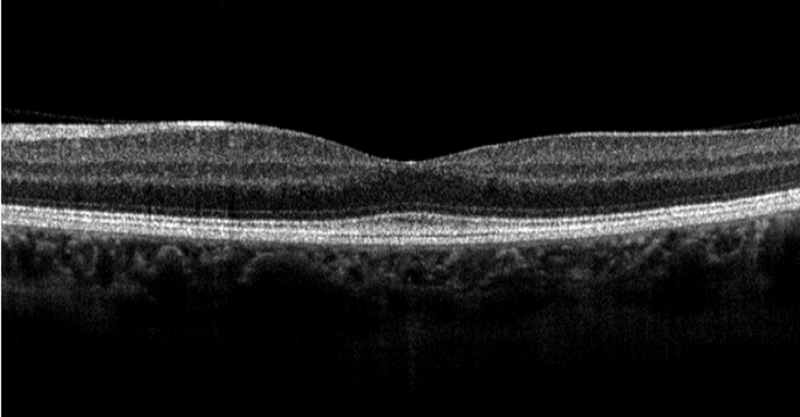

Volumen 22 - Número 4 - Octubre - Noviembre 2014
Lesión macular en madre e hija
C. Hernández MartÃnez, J. Catalá-Mora
Hospital Sant Joan de Déu. Esplugues de Llobregat. Barcelona.
CORRESPONDENCIA
Carmen Hernández Martínez
E-mail: carmenhm1985@gmail.com
E-mail: carmenhm1985@gmail.com
Niña de 5 años remitida a nuestro hospital por sospecha de estrabismo. La agudeza visual con corrección era de 0,8 en ambos ojos, el cover test mostró una ortotropia lejos y cerca con versiones sin alteraciones. La biomicroscopia resultó normal y en la exploración de fondo de ojo hallamos lo siguiente:

Figura 1a.

Figura 1b.
¿Cuál es el diagnóstico de sospecha?
a) Enfermedad de Stargardt
b) Distrofia viteliforme de Best
c) Drusas cuticulares
d) Distrofia en patrón
Respuesta correcta: b
La distrofia viteliforme de Best es la segunda distrofia macular más común después de la enfermedad de Stargart. Ha sido clasificada en 5 estadios, pero eso no implica que siempre tenga que evolucionar de un estadio al siguiente, a su vez dentro de un mismo paciente puede haber asimetría entre los dos ojos, como es el caso de nuestra paciente, donde el ojo derecho se encuentra un estadio 3 (viteloruptivo, con pseudohipopión “huevo revuelto”) y el ojo izquierdo estadio 2 (lesión blanco-amarillenta viteliforme clásica). El resto de estadios son estadio 0 (no lesión evidente en fondo de ojo con alteración en el electrooculograma (EOG), estadio 1 (leve alteración del epitelio pigmentado de la retina (EPR), con defecto ventana en autofluorescencia), estadio 4 (atrofia geográfica con o sin NVC).La niña vino acompañada de su madre a la cual exploramos basándonos en nuestro diagnóstico de sospecha, hallando las siguientes imágenes:

Figura 2a.

Figura 2b.
Las imágenes muestran una distrofia viteliforme en estadio 4 en ojo izquierdo lo que nos permite confirmar el diagnóstico pues sabemos que la distrofia viteliforme de Best tiene una herencia autosómica dominante, con mutación en el gen BEST1 o también llamado VMD2, un gen localizado en el cromosoma 11q13 que codifica la proteína bestrofina, un canal transmembrana de cloro dependiente de calcio localizado en la membrana basolateral de las células del EPR. Su disfunción provoca el depósito de material amarillento en el EPR que histopatológicamente se corresponde con lipofucsina.
Aunque muchas veces el diagnóstico se establece por las imágenes de fondo de ojo, en otros casos más incipientes o con lesiones menos típicas el EOG es de gran utilidad. El test se basa en la medida del potencial eléctrico generado a través de las células del EPR y es expresado por el ratio Arden, en los pacientes con distrofia de Best , el ratio de Arden es menor de 1,5. Este hallazgo precede a las lesiones visibles en el fondo de ojo1.
El hecho de que la afectación materna sea unilateral puede ser explicado por una nueva mutación en el gen BEST1 o mutación de otro gen diferente como describen en la literatura2,3.
También obtuvimos imágenes de tomografía de coherencia óptica de madre e hija:

Figura 3a.
Figura 3b.
Figura 4a

Figura 4b.
¿Qué hallazgos tomográficos se pueden describir?
a) Imagen hiperreflectiva en línea de los elipsoides de los segmentos internos (ESI)
b) Discontinuidad de la línea ESI
c) Retinosquisis en capas internas de la retina
d) Área hiperreflectiva por encima del EPR y desprendimiento seroso de retina sensorial adyacente
e) B y D son ciertas
Respuesta correcta: e
En la imagen de OCT de la hija (Figura 3a y Figura 3b) vemos una imagen hiperreflectiva por encima del EPR, más heterogénea en OD (estadio viteloruptivo) y fijándonos en la línea ESI ésta está integra en ambos ojos, no es el caso de la madre (Figura 4b) donde vemos una discontinuidad. La imagen de OCT del ojo derecho (Figura 4a) de la madre no muestra hallazgos patológicos.La agudeza visual de estos pacientes en fases iniciales está bastante conservada pese a los hallazgos en el fondo de ojo y esto puede estar condicionado por la integridad de la línea ESI hasta fases más avanzadas de la enfermedad y por la aparición también de neovascularización coroidea. Es por ello que se aconseja a todo paciente con enfermedad de Best en cualquier estadio que hagan autocontroles con rejilla de Amsler para una detección precoz de esta complicación.
El resto de opciones descritas en la pregunta son hallazgos tomográficos descritos en la literatura en la distrofia de Best5.
Bibliografía
- Jesse L Berry; berry and Armani Fawzi. "Heritable Disorders of the Retinal Pigment Epithelium, Bruch's Membrane, and the Choriocapillaris". Kenneth W. Wright; Yi Ning J. Strube. Pediatric Ophthalmology and Strabismus. 3th Edition. New York: Oxford University Press, 2012.
- Cascavilla ML, Querques G, Stenirri S, et al. Unilateral Vitelliforma phenotype in autosomal recessive bestrophinopathy. Ophthalmic Res. 2012;48(3):146-50.
- Subash M1, Rotsos T, Wright GA, Devery S, Holder GE, et al. Unilateral vitelliform maculopathy: a comprehensive phenotype study with molecular screening of BEST1 and PRPH2. Br J Ophthalmol. 2012 May;96(5):719-22.
- Haifen Xu, Liang Ying, Ping Lin et al. Optical Coherence Tomography for Multifocal Vitelliform Macular Dystrophy. Optom Vis Sci. 2013 Jan;90(1):94-9.